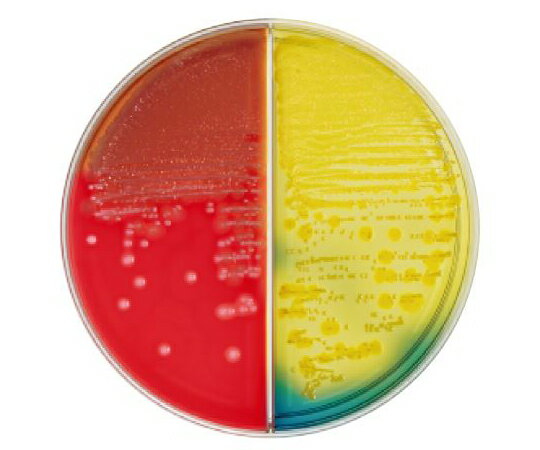
ベクトン・ディッキンソン BD BBL(TM) TSA5%ヒツジ血液寒天培地/BTB乳糖加寒天培地 20枚 1個(1本×20枚入) 258281

“`html
【2025年12月02日】楽天設備ランキング速報!賢く選ぶための詳細ガイド
2025年12月02日、楽天の設備ランキングは、日中に51件の商品が更新されるなど、活発な動きを見せています。この時間の価格帯は¥150から¥22,275と幅広く、平均価格は¥7,445となっています。昼の時間帯ならではの、実用的でコストパフォーマンスに優れた商品が上位を占める傾向が見られます。
設備ジャンルの特徴と商品選びのポイント
「設備」というジャンルは、文字通り、生活や仕事の基盤となる設備機器や関連パーツを幅広く含みます。DIY用品、建築資材、電気部品、工具、さらにはオフィス用品まで多岐にわたります。商品選びの際は、まず用途を明確にすることが最重要です。次に、耐久性、機能性、そして互換性を確認しましょう。特にDIYや修繕においては、既存の設備との互換性がスムーズな作業を左右します。
価格帯別・上位商品の詳細分析
今回のランキング上位3商品は、まさにこのジャンルの多様性と実用性を象徴しています。
- 1位:オムロン(OMRON)S8FS-G10024CD-500 スイッチングパワーサプライ (¥6,402)
産業用電源の代表格であるオムロンのスイッチングパワーサプライが堂々の1位。信頼性の高いブランドであり、産業機器や自作PCなど、安定した電源供給が求められる場面で活躍します。この価格帯で、この品質の製品が入手できるのは注目に値します。
- 2位:NTY メタルジョイント NTY-7B ブラック Φ28mm用 (¥400)
DIY愛好家や小規模な棚などを自作する際に非常に便利なメタルジョイント。イレクターメタルジョイントとの互換性がある点が、既存のパーツを活かせるという点で大きなメリットです。
- 3位:NTY メタルジョイント NTY-1B ブラック Φ28mm用 (¥150)
こちらはT字型のジョイント。NTY-7Bと同様に、Φ28mmパイプに対応し、DIYの自由度を格段に広げます。この驚異的な低価格は、ちょっとしたアイデアを形にするのに最適です。
上位3商品を見ると、高機能な電源ユニットから、低価格でDIYの可能性を広げるパーツまで、幅広いニーズに応える商品がランキングを賑わっていることがわかります。
購入タイミングと具体的なおすすめポイント
今回のランキングは、日中の更新で多様な商品が登場しており、特にDIY関連や、仕事で必要なパーツを急ぎで探している方には、この時間帯のチェックがおすすめです。¥150からという驚きの価格帯の商品は、まさに「今すぐ必要!」というニーズに応えうるものです。また、オムロンのパワーサプライのような高価格帯の商品は、セールやポイントアップのタイミングを狙うことで、さらにお得に購入できる可能性もあります。楽天の設備ランキングは、単なる人気順ではなく、実用性とコストパフォーマンスを兼ね備えた商品が評価される傾向にあります。ご自身の用途に合わせて、ランキングを賢く活用し、お得な設備選びをお楽しみください。
“`

オムロン(OMRON)S8FS-G10024CD-500 スイッチングパワーサプライ
6402円

NTY メタルジョイント NTY-7B ブラック Φ28mm用 (イレクターメタルジョイントのHJ-7と互換性あり) メタルラック パーツ 組立て パイプジョイント パイプ フリージョイント 継手 DIY 棚 中量 軽量 ラック インテリア 収納
400円

NTY メタルジョイント NTY-1B ブラック Φ28mm用 (イレクターメタルジョイントのHJ-1と互換性あり) メタルラック パーツ 組立て パイプ T字 ジョイント 継手 DIY 棚 中量 軽量 ラック インテリア 収納
150円

NTY メタルジョイント NTY-2B ブラック Φ28mm用 (イレクターメタルジョイントのHJ-2と互換性あり) メタルラック パーツ 組立て パイプ コーナー ジョイント 継手 DIY 棚 中量 軽量 ラック インテリア 収納
200円

ONiLAB エコノミー電動攪拌機 OS10 攪拌量10L 回転数100-2500rpm 最大撹拌粘度:10000 mPas 高粘度溶の液体攪拌 攪拌機用プレートスタンド+攪拌機用羽根2本 電源100V(50/60Hz)化粧品製造/石油/化学/冶金/繊維/環境保護 科学研究 産業研究用
22275円

中川製袋化工 タイヨーのポリ袋 1ケース(30枚×20袋入) 04 NO65
20048円

エリエール ドリップペーパー エコック 無漂白250枚*4 410mm*600mm 21000199
6887円
![トラスコ中山 【20本販売】TRUSCO 箱売り リチウム万能グリス #2 420ml 20本単位 TCG-400L [1-123-0867]](https://thumbnail.image.rakuten.co.jp/@0_mall/daishinshop/cabinet/item/001-99/1-123-0867.jpg?_ex=128x128)
トラスコ中山 【20本販売】TRUSCO 箱売り リチウム万能グリス #2 420ml 20本単位 TCG-400L [1-123-0867]
12706円

スズラン 滅菌Sガーゼ リリアン 3号 1箱(10袋×10個) 13210305 1箱(10袋×10個入)
3582円

アイリスオーヤマ ステンレス物干し竿 ブルー 1700〜3000×φ42mm 1本 SU-300F
1808円
ベクトン・ディッキンソン BD BBL(TM) TSA5%ヒツジ血液寒天培地/BTB乳糖加寒天培地 20枚 1個(1本×20枚入) 258281
6605円

NTY メタルジョイント NTY-13B ブラック Φ28mm用 パイプラック ジョイント 組立て パイプ フラットサドル メタルラック パーツ 棚受け金具 継手 DIY 棚 中量 軽量 ラック インテリア 収納
200円

dretec IHクッカー ミニチュラ ブラック DI-218BK
6534円

TENMA とっても便利箱 45S ロング カプチーノ 811000921 1個 ▼836-0016
2818円

三彩化工 サンジェット P-1000 金属表面研磨剤 1kg
4836円

【在庫有・即納】トラスコ中山 TRUSCO 薄型折りたたみ コンテナ スケルコン スケルトンコンテナ 透明 ブラック 50L ロックフタ付 TSK-C50B-BK 収納 オリコン
1598円

【在庫有・即納】トラスコ中山 TRUSCO 薄型折りたたみ コンテナ スケルコン スケルトンコンテナ 透明 ブラック 50L ロックフタ付 TSK-C50B-BK 収納 オリコン
1580円
![プラスチックラック スリム3段 ブラック PLR-7203 アイリスオーヤマ [軽量 収納 棚 整理 ガーデニング シューズラック 倉庫 ]](https://thumbnail.image.rakuten.co.jp/@0_mall/hc7/cabinet/2025-9-a/4967576780513.jpg?_ex=128x128)
プラスチックラック スリム3段 ブラック PLR-7203 アイリスオーヤマ [軽量 収納 棚 整理 ガーデニング シューズラック 倉庫 ]
4503円

NTY メタルジョイント NTY-15B ブラック Φ28mm用 組立て パイプラック ジョイント パイプ 継手 DIY 棚 メタルラック パーツ 中量 軽量 ラック インテリア 収納
200円

和平フレイズ 彩食庵Fパン用蓋付蒸し台(24〜26用) 1個
3988円
![アズワン AS ONE Jボトル角型 細口 遮光 1L 15-6004-55 [1445-0082758]](https://thumbnail.image.rakuten.co.jp/@0_mall/daishinshop/cabinet/item/1445-100/1445-0082758.jpg?_ex=128x128)
アズワン AS ONE Jボトル角型 細口 遮光 1L 15-6004-55 [1445-0082758]
296円

ELEGOO 高速 PETG フィラメント 1.75mm 半透明 印刷速度600mm/s対応可能 RAPID PETG フィラメント 3D プリンター用フィラメント 寸法精度±0.02mm ほとんどのFDMプリンターに対応 (1KG/スプール 2.2 lbs)
2331円

【お取り寄せ】矢崎化工 イレクター 28メタリックパイプ 900mm パールシルバー 支柱 クランプ 機構部品 メカニカル部品 作業用品 工具
1089円
![TJMデザイン タジマ コーキングガン コンボイJ900 CNV-J900 [50-065919]](https://thumbnail.image.rakuten.co.jp/@0_mall/daishinshop/cabinet/item/050-2/50-065919.jpg?_ex=128x128)
TJMデザイン タジマ コーキングガン コンボイJ900 CNV-J900 [50-065919]
1917円

【送料無料】硬度指示薬溶液25mL
1900円

プラスチックトレー ブラック | 収納 保管 整理 整頓 アストロプロダクツ
1760円

サムコス シリコーンチューブ 内径 8mm 外径 10mm 長約2M 透明 シリコンホース エアーポンプ パイプ ウォーターホース 多用途 耐熱 耐候 高弾力 ゴムチューブ
1694円

廣杉計器 黄銅スペーサー M3用 25mm 1個 ASB325E
154円

【正規品】オムロン PYF14A 共用ソケット
488円

シリコーン折畳マグネットトレー | トレー シリコン 小物収納 折りたたみ 底面マグネット付き 【レッド ブラック オレンジ グリーン ブルー】 アストロプロダクツ
649円

NTY メタルジョイント NTY-3B ブラック Φ28mm用 (イレクターメタルジョイントのHJ-3と互換性あり) パイプラック ジョイント パイプジョイント 組立て メタルラック パーツ パイプ 継手 DIY 棚 中量 軽量 ラック インテリア 収納
300円

【楽天1位】時計工具 導電性マット SEIKO セイコー A-KTZ 003 腕時計 修理 オーバーホール メンテナンス
1155円

シシベラマスク 冷感マスク 不織布 3dマスク バイカラーマスク 20枚入 花粉対策マスク 不織布 小さめ 使い捨てマスク モカブラウン×紐ブラウン
907円

日本ケミコン アルミ電解コンデンサー 25V 100μF 85℃ 耐洗浄(10個1セット) 1セット(10個入) ESMG250ELL101MF11D*A
867円

AZ(エーゼット) 超強力ラベルはがし 雷神 スプレー 420ml シールはがし ラベルリムーバー ラベル除去 シール除去
842円

ロジック|Logic TSAダイヤルロック南京錠 4ダイヤル シルバー LG-PLK-TSA-4DL-SV
825円

クー・メディカル・ジャパン 全国マスク工業会会員不織布 マスク KOO(クー)プレミアムソフトマスク ふつうサイズ 60枚入
677円

TRUSCO(トラスコ) メスシリンダー 10ml 青目盛付 PP製 MS10
642円

BESCO ハードワックス-ジェイ スタンダード J-103 1個
615円

【ミゼットヒューズ用5本セット】 ヒューズホルダー Φ5.2×20mm ミニ管 ヒューズソケット ミゼット型 ガラス管 ヒューズ用
544円

アラム ミニコネクター MC-10 S型パネルタイプ 3.0-3.0mm 10個入 1袋(10個入) MCSP30
414円

その他 ツマミ 14Φ 黒 CP-BX-MB6-S(6.1)W7 1個
322円

アルミ スペーサー 10個 M6 内径6.2mm×外径10mm×長さ4mm ネジスタンドオフブッシング プ レーン仕上げの丸型スペーサー ネジ ボルト
1540円

NTY メタルジョイント NTY-15B ブラック Φ28mm用 組立て パイプラック ジョイント パイプ 継手 DIY 棚 メタルラック パーツ 中量 軽量 ラック インテリア 収納
200円

オムロン PF083A 共用ソケット
750円

AZ(エーゼット) グリーススプレー シルバー 420ml 二硫化モリブデン配合 長期潤滑 耐熱・耐水・防錆 144
655円

NTY メタルジョイント NTY-3B ブラック Φ28mm用 (イレクターメタルジョイントのHJ-3と互換性あり) パイプラック ジョイント パイプジョイント 組立て メタルラック パーツ パイプ 継手 DIY 棚 中量 軽量 ラック インテリア 収納
300円
![トラスコ中山 TRUSCO 1本売り シャーシーグリース #1 420ml TCG-400-1P [1-409-8846]](https://thumbnail.image.rakuten.co.jp/@0_mall/daishinshop/cabinet/item/001-8/1-409-8846.jpg?_ex=128x128)
トラスコ中山 TRUSCO 1本売り シャーシーグリース #1 420ml TCG-400-1P [1-409-8846]
523円

NTY メタルジョイント NTY-13B ブラック Φ28mm用 パイプラック ジョイント 組立て パイプ フラットサドル メタルラック パーツ 棚受け金具 継手 DIY 棚 中量 軽量 ラック インテリア 収納
200円

3M スコッチ・ブライト セルロースクロス デザインシリーズ ピンク・オレンジ各1枚入 CCL-D2
353円

【訳あり特価品】工進 充電式草刈機PBC用 チップソー固定ナット 1個 PA-441
242円